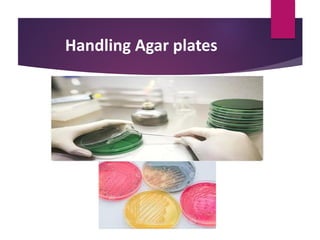
Handling Agar plates

The document provides instructions and information about laboratory techniques, microscopy, and bacteria. It discusses aseptic technique, handling materials safely. It describes the main components of a microscope, including the stage, illumination, condenser, body tube, and objectives. It explains magnification, resolving power, and the use of oil immersion lenses. It outlines different types of microscopes including optical, UV, electron, and dark ground. Finally, it discusses bacteria, describing common shapes like cocci, bacilli, and spirals, and how they can be arranged.